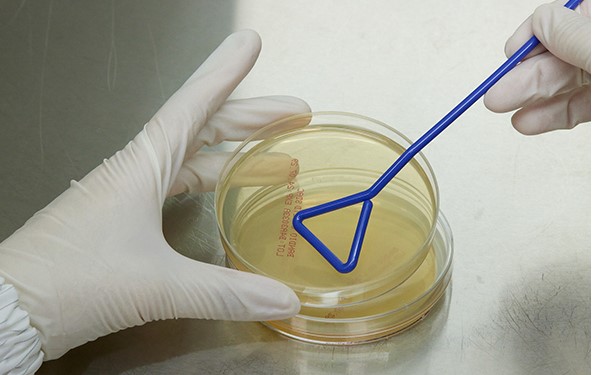

Korean Cosmetics K-Beauty
K-Beauty Export Strategies: Targeting the U.S. and Middle Eastern Markets
The demand for Korean cosmetics (K-Beauty) continues to rise in both the United States and the Middle East, driven by product quality, innovative ingredients, and the global influence of Korean culture.
In particular, small and medium-sized enterprises (SMEs) and wholesalers are sourcing Korean cosmetics through various channels, with diverse preferences for brands and ingredients. To successfully enter these markets, strategies tailored to regional characteristics and consumer preferences are essential.**

Preferred Korean Cosmetic Brands and Ingredients
Preferred Brands
- COSRX: Renowned for products suitable for sensitive skin, including effective ingredients for acne treatment.
- Sulwhasoo: A premium brand based on traditional Korean herbal medicine, particularly popular in the Middle East.
- Innisfree: Emphasizes natural ingredients, resonating with eco-friendly images in both the U.S. and Middle East.

Preferred Ingredients
- Snail Mucin: Effective for skin regeneration and hydration, highly favored by U.S. consumers.
- Red Ginseng Extract: Aids in anti-aging and improving skin elasticity, preferred in the Middle East.
- Centella Asiatica (Cica): Effective for soothing and healing the skin, gaining global popularity.


Popular Beauty Products and Key Ingredients in the U.S.
Mielle Organics Rosemary Mint Scalp & Hair Strengthening Oil
- Key Ingredients: Rosemary Oil, Peppermint Oil, Biotin
- Benefits: Enhances scalp circulation, promotes hair growth, prevents hair loss
- Features: Notable hair growth effects within 6 weeks, over 80,000 five-star reviews
CeraVe Hydrating Facial Cleanser
- Key Ingredients: Ceramides, Hyaluronic Acid
- Benefits: Strengthens skin barrier, provides hydration
- Features: Suitable for sensitive skin, gently cleanses the skin

Paula's Choice Skin Perfecting 2% BHA Liquid Exfoliant
- Key Ingredient: Salicylic Acid
- Benefits: Exfoliates dead skin cells, cleanses pores, prevents acne
- Features: Powerful yet gentle exfoliant, can be used twice daily
The Ordinary Niacinamide 10% + Zinc 1%
- Key Ingredients: Niacinamide, Zinc
- Benefits: Improves skin tone, controls sebum, reduces pore size
- Features: Offers high-efficacy ingredients at an affordable price

COSRX Advanced Snail 96 Mucin Power Essence
- Key Ingredient: Snail Mucin Filtrate
- Benefits: Skin regeneration, hydration, improves elasticity
- Features: A K-Beauty product used by celebrities like Ariana Maddix
Popular Skincare Ingredients in the U.S.
- Salicylic Acid: Effective for acne treatment and exfoliation, cleanses pores for smoother skin.
- Retinol: Helps reduce wrinkles and improve skin elasticity, promotes cell regeneration.
- Hyaluronic Acid: Maintains excellent moisture retention, keeps skin hydrated and firm.
- Niacinamide: Evens skin tone, controls sebum production, reduces pore size.
- Vitamin C: Improves skin brightness and provides antioxidant effects, maintaining healthy skin.
- Ceramides: Strengthen the skin barrier and prevent moisture loss, protecting the skin.
- Peptides: Promote collagen production, improve skin elasticity, reduce wrinkles.
- Snail Mucin: Effective for skin regeneration and hydration, enhances skin elasticity.

Consumer Preference Analysis
U.S. Consumers Prefer:
- Scientifically Proven Ingredients: High trust in products containing proven effective ingredients.
- Suitable for Sensitive Skin: Preference for products with low irritation that strengthen the skin barrier.
- Multi-functional Products: Increasing demand for products that address multiple skin concerns simultaneously.
- Interest in K-Beauty Products: Continuous growing interest in Korean skincare products and ingredients.


Preferred Korean Cosmetic Ingredients and Their Effects Among U.S. Consumers
- Snail Mucin
- Benefits: Promotes skin regeneration, provides hydration, reduces wrinkles, alleviates scars.
- Features: Contains glycoproteins, hyaluronic acid, and antimicrobial peptides to keep skin hydrated and repair damaged skin.
- Representative Product: COSRX Advanced Snail 96 Mucin Power Essence
- Centella Asiatica (Cica)
- Benefits: Soothes skin, reduces inflammation, strengthens skin barrier.
- Features: Contains madecassoside and asiatic acid to calm and aid skin recovery.
- Representative Product: Skin1004 Madagascar Centella Ampoule




Summary of Preferred Ingredients in Korean Cosmetics Among U.S. Consumers
| Snail Mucin | Skin regeneration, hydration, wrinkle reduction | COSRX Advanced Snail 96 Mucin Power Essence |
| Centella Asiatica | Soothes skin, reduces inflammation, strengthens barrier | Skin1004 Madagascar Centella Ampoule |
| Propolis | Antibacterial, antioxidant, skin protection | Beauty of Joseon Glow Serum: Propolis + Niacinamide |
| Hyaluronic Acid | Hydration, improves skin elasticity | COSRX Hyaluronic Acid Intensive Cream |
| Niacinamide | Improves skin tone, controls sebum, reduces pores | Anua Niacinamide 10% + TXA 4% Serum |
| Green Tea | Antioxidant, anti-inflammatory, soothes skin | Innisfree Green Tea Seed Serum |
| Mugwort | Soothes skin, reduces inflammation, provides hydration | I'm From Mugwort Essence |
| Red Ginseng | Improves skin elasticity, reduces wrinkles, revitalizes skin | Sulwhasoo Concentrated Ginseng Renewing Serum |

Top 7 K-Beauty Products Preferred by Overseas Buyers
Sunscreen
- Key Ingredients: Zinc Oxide, Titanium Dioxide (non-irritating physical UV filters), Niacinamide (brightening), Centella Asiatica (soothing), Hyaluronic Acid (hydration)
- Why It's Popular: Lightweight, non-greasy, and non-whitening formulas have made Korean sunscreens a hit in the U.S. and Europe. Products registered with the FDA and certified with PA++++ are especially favored. The perception that "Korean sunscreen is light, effective, and elegant" is spreading.
Whitening / Tone-Up Cream
- Key Ingredients: Niacinamide, Arbutin, Glutathione (brightening agents), Pearl Powder (radiance), Vitamin C derivatives
- Why It's Popular: Provides immediate skin tone-up effects and long-term brightening with continued use. The natural and fair complexion achieved aligns with Korean beauty aesthetics, which is especially appealing in hotter countries where there's a higher demand for bright and luminous skin tones.

Cleansing Foam / Oil / Gel
Key Ingredients: Amino Acid Surfactants, Green Tea, Mugwort Extract (natural origins), Tea Tree Oil (trouble care), Ceramide (moisture protection)
Why It's Popular: Offers gentle, mildly acidic cleansing without residue. Effectively removes makeup without the need for double cleansing. Reflects the "Clean Beauty + Natural Ingredients" trend
Sheet Mask
Key Ingredients: Hyaluronic Acid (intense hydration), Collagen, Centella, Snail Mucin, Chamomile, Aloe Vera (soothing), Vitamin C
Why It's Popular: Delivers noticeable effects with just one use, making it ideal for trial products. The combination of affordability and high quality leads overseas buyers to import in bulk. Widely consumed in spas, hotels, and markets.
Ampoule / Serum
Key Ingredients: Peptides, EGF, Retinol, Propolis, Niacinamide, Madecassoside
Why It's Popular: Korea is recognized as the "country of serums." These high-functionality concentrated formulas are suitable for use in luxury spas and beauty salons. European buyers are actively purchasing these products.
Moisturizing Cream / Calming Cream
Key Ingredients: Panthenol (D-Panthenol), Centella, Ceramide, Madecassoside
Why It's Popular: With a global increase in consumers with sensitive skin, these creams address issues like eczema and redness. The perception that "Korean soothing skincare is gentle and effective" is widespread.
Multi Balm / Lip Balm / Stick Type
Key Ingredients: Shea Butter, Jojoba Oil, Vitamin E, Cica
Why It's Popular: Aligns with the "On-the-go skincare" trend. Appeals to Gen Z and minimalists. The stick-type design and portability are highly popular.
"A Trusted Korean Cosmetics Manufacturer with Advanced Technology"
Are you looking for a Korean cosmetics manufacturer with excellent technology and the ability to meet the needs of U.S. buyers and retailers?
Introducing Bobik Korea, a leading Korean cosmetics manufacturer and a trustworthy partner.


Beauvique Korea is a specialized cosmetics company and your global partner for OEM and customized OEM solutions.
We are committed to meeting our clients' needs, from product development to export solutions.
We strive to grow together and develop better products.




PF Nature's production line manufactures various skincare products.
Our skincare production line includes 9 different types, 3 types of mask packs,
and 3 types of sticks, allowing us to consistently meet delivery deadlines for
clients worldwide.




GLOBAL STANDARD OF BEST QUALITY
We manufacture reliable products through quality management that considers overseas market regulations and standards.

With the latest facilities, we, Bobique Korea, have our own brand, Bobique, and produce famous brand beauty products from around the world and in Korea. We collaborate with designers with decades of experience and bring design to your products.

















Our Beauvique Korea manufactures and supplies the cosmetics or whole things of Korean products that customers want. Please feel free to contact us.
Thank you

e-mail : beauviquekorea@gmail.com
#korea beauty#k-beauty#korea cosmetics#k-beauty korea#cosmetics expo korea#k-beauty online shop# korea cosmetics manufacturer#koreacosmetics skintific#korean cosmetics#korean sunscreen